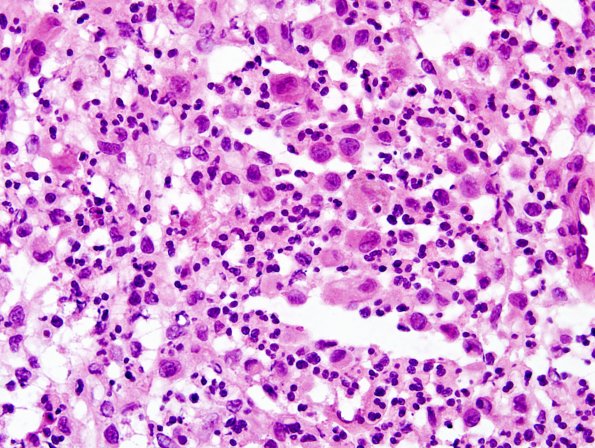
22A2 LCH (Case 22) H&E frozen 1.jpg

Table of Contents
Washington University Experience | NEOPLASMS (HEMATOLYMPHOID) | Langerhans Cell Histiocytosis (LCH) | 22A2 LCH (Case 22) H&E frozen 1.jpg
H&E stained slides of the clival mass show sheets of Langerhans histiocytes with eosinophilic cytoplasm, oval nuclei with longitudinal grooves as well as abundant eosinophils, lymphocytes and neutrophils.